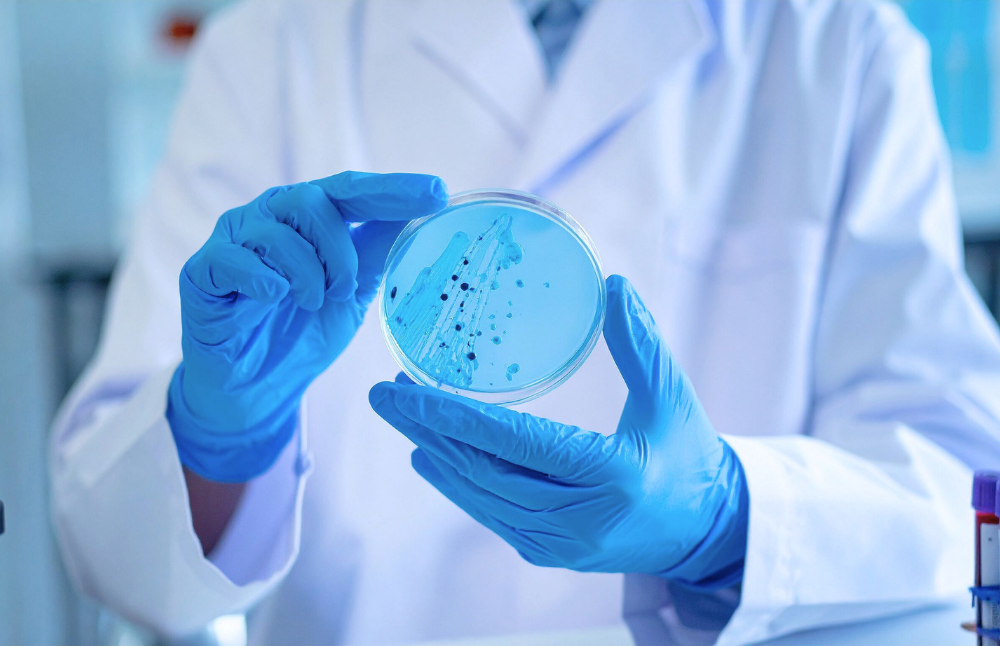
Otro de los proyectos que se ejecutarán en el marco de Anillos Regulares es “NanoAIR Center: Nanocarrier Advanced Inhalation Research Center”, dirigido por el académico de la Facultad de Ciencias Químicas y Farmacéuticas, Prof. Javier Morales.

La Agencia Nacional de Investigación y Desarrollo (ANID) desarrolla los concursos Anillos Regulares y Anillos Temáticos con el objetivo de fortalecer la investigación científica y tecnológica del país. Estas iniciativas apoyan la ejecución de proyectos que transiten desde la investigación básica a la investigación aplicada, fomentando la colaboración entre la academia y el sector productivo, además de promover la conformación de grupos de investigación y la formación de capital humano avanzado.
En los recientes resultados de adjudicación, la Universidad de Chile destacó al representar el 20% de las iniciativas adjudicadas en el concurso Anillos Temáticos, con participación en cinco de las 25 seleccionadas en el país. De ellas, tres en calidad de institución asociada y dos como institución principal.
Estas últimas serán lideradas por las facultades de Ciencias y de Ciencias Veterinarias y Pecuarias: “Soluciones biotecnológicas para la adaptación y resiliencia de las plantas al estrés térmico e hídrico” y “Riesgos emergentes en la Antártica y la región subantártica: evaluación de patógenos y contaminantes en la fauna silvestre mediante vigilancia activa”.
En el concurso Anillos Regulares, la Casa de Bello obtuvo el 13% de las adjudicaciones nacionales, liderando la participación como institución principal con los proyectos: “Iluminación azul y blanca: dispositivos que utilizan complejos inorgánicos como tratamiento eficaz contra la bacteria Klebsiella pneumoniae y el hongo Monilinia laxa en nectarinas”, y “NanoAIR Center: Nanocarrier Advanced Inhalation Research Center”, que serán desarrollados por las facultades de Ciencias y de Ciencias Químicas y Farmacéuticas, respectivamente. Como institución asociada, la Universidad será parte de la iniciativa de la Universidad de Santiago titulada “Nueva plataforma para la diversificación y sostenibilidad de la industria biotecnológica de levaduras en Chile”.
Al respecto, el director de Investigación de la U. de Chile, profesor Rómulo Fuentes, señaló que “este logro refleja el compromiso de nuestras académicas y académicos y la capacidad de la Universidad de Chile, como institución pública, para liderar la creación de conocimiento relevante para el país y para el mundo”. Igualmente, Fuentes destacó el carácter asociativo de estos proyectos, “ya que la ciencia progresa a través de la colaboración”.
Experiencias en la creación de conocimientos
Dentro de los proyectos que serán ejecutados por la Casa de Bello en áreas temáticas, destaca “Soluciones biotecnológicas para la adaptación y resiliencia de las plantas al estrés térmico e hídrico”. Esta investigación buscará mejorar la resiliencia de los cultivos ante el estrés hídrico y térmico, mediante el desarrollo e integración de tecnologías avanzadas de edición genética y bioestimulantes naturales.
La iniciativa será liderada por la académica de la Facultad de Ciencias, profesora Claudia Stange, y contará con la colaboración de las universidades de Santiago y Pontificia Católica de Valparaíso.
Al respecto, la profesora Stange indicó que “los sistemas agrícolas de Chile se ven cada vez más amenazados por la persistente escasez de agua y las altas temperaturas, factores de estrés que afectan de manera desproporcionada a las regiones centrales del país. Para abordar estos impactos se requieren soluciones escalables y basadas en la ciencia que integren enfoques genéticos, bioquímicos y territoriales”.
Para esto, se estudiarán tres cultivos estratégicos nacionales e internacionales —tomate, manzana y aguacate— integrando tecnologías avanzadas de edición genética y bioestimulantes naturales. “Estas aplicaciones serán evaluadas en colaboración con pequeños y medianos productores de las regiones de Valparaíso, Metropolitana y O’Higgins, en conjunto con organizaciones como INDAP, Pefruts y Biofrutales”, agregó Stange.
Otro de los proyectos que se ejecutarán en el marco de Anillos Regulares es “NanoAIR Center: Nanocarrier Advanced Inhalation Research Center”, dirigido por el académico de la Facultad de Ciencias Químicas y Farmacéuticas, profesor Javier Morales. La iniciativa contará con la colaboración de las universidades de Valparaíso, San Sebastián y Tecnológica Metropolitana, así como también del Instituto de Salud Pública y la Sociedad Chilena de Neumología Pediátrica (SOCHINEP).
El proyecto buscará generar una formulación para el tratamiento de infecciones resistentes por Pseudomonas aeruginosa, que afectan a pacientes con afecciones respiratorias como la fibrosis quística. Al respecto, el profesor Morales señaló que “las terapias actuales no son perfectamente eficaces. Entonces, la nanotecnología que proponemos mejora las características de accesibilidad de los fármacos en el sitio de la infección, para que puedan mejorar su desempeño terapéutico”.
Asimismo, el especialista recalcó el impacto futuro del proyecto: “Podría ser un posible tratamiento para esta particular enfermedad o para una infección pulmonar por Pseudomonas. Pero, a su vez, el propósito de la investigación es generar un sistema de transporte respirable a través del desarrollo de nebulizadores, lo cual también podría ser transferible a otras enfermedades respiratorias, pues la tecnología que estamos desarrollando será una plataforma adaptable a diversas afecciones pulmonares”.
“NanoAIR nace desde la colaboración sostenida, reuniendo equipos interdisciplinarios, y articulando trabajo conjunto con la industria e instituciones de diversas regiones del país. Este enfoque permite abordar el problema desde múltiples aristas y, al mismo tiempo, constituye un espacio formativo para estudiantes e investigadores mediante tesis, proyectos dirigidos y capacitación práctica”, aseguró el profesor Morales.